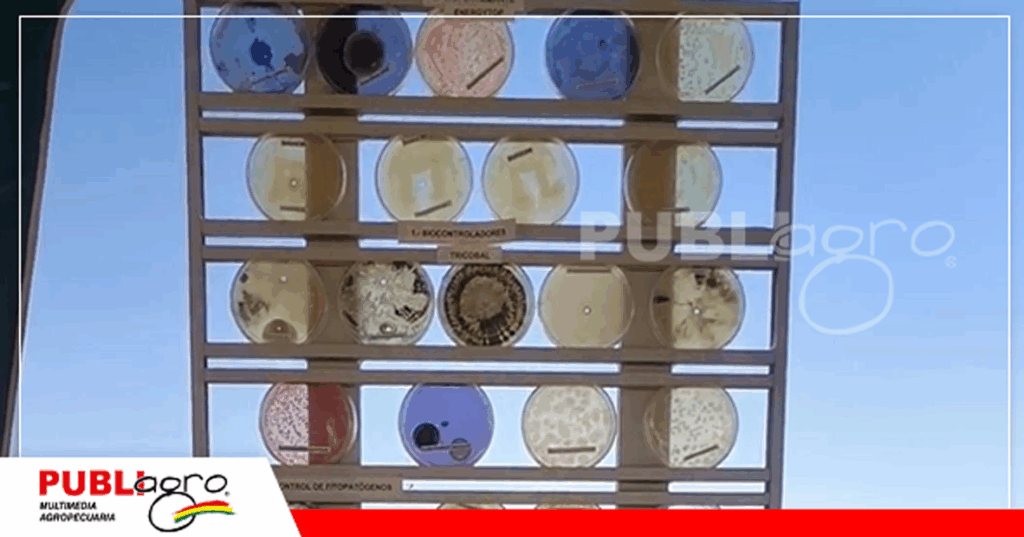
Foto: Publiagro

Proinpa impulsa el uso de microorganismos nativos como alternativa ecológica y económica para el control de plagas y enfermedades, mejorando el rendimiento y la calidad de los cultivos en todo el país

En un contexto global cada vez más afectado por la preocupación ambiental, el agotamiento progresivo de los suelos y la creciente resistencia a agroquímicos sintéticos, los bioinsumos emergen como una herramienta clave para promover una agricultura más sostenible, eficiente y respetuosa con el medio ambiente.
Oscar Navia, ingeniero e investigador de la Fundación Proinpa, destacó que los bioinsumos representan no solo una alternativa ecológica, sino también una innovación tecnológica que permite enfrentar eficazmente múltiples desafíos agrícolas. Según explicó, “los bioinsumos, además de ser una innovación, permiten controlar eficientemente enfermedades de suelo, plagas e insectos, permitiendo buen desarrollo de los cultivos, buen rendimiento y buen beneficio económico para los productores”.
Estos productos biológicos están compuestos por microorganismos benéficos que son obtenidos de diversas zonas productivas del país. En el caso de Proinpa, se lleva a cabo un muestreo en diferentes regiones de Bolivia con el objetivo de identificar aquellas cepas nativas capaces de enfrentar enfermedades y plagas. Una vez recolectadas, se analizan para determinar cuáles de ellas ofrecen beneficios concretos a los cultivos.
«Una vez que identificamos cuáles son los benéficos, pasan a unos equipos especiales que son los biorreactores, que vuelven millones el microorganismo seleccionado y luego ya es formulado para que pueda ser aplicado a los cultivos», explicó Navia.

“La respuesta de los productores a estos productos es muy buena, ya que estamos hablando del futuro de la agricultura. Cada vez el mundo exige más alimentos, pero alimentos más sanos, y los bioinsumos te permiten producir alimentos más sanos porque no afectan al medio ambiente ni al desarrollo del producto, y permiten mayor calidad”


Proinpa trabaja con una amplia gama de microorganismos específicos, adaptados a distintas necesidades agrícolas. Por ejemplo, para el control de patógenos de suelo, utilizan cepas como Trichoderma harzianum y Trichoderma koningiopsis, así como Bacillus spp. En el caso de enfermedades foliares, se formulan productos que contienen un “mix de bacterias muy buenas para controlar todo lo que es enfermedades foliares como la roya, mancha anillada, antracnosis, piricularia en el trigo y otras”.
En cuanto al manejo de plagas, también se han desarrollado bioinsumos basados en Beauveria bassiana y otros hongos entomopatógenos, demostrando una amplia versatilidad en su aplicación a diferentes tipos de cultivos.
Navia resaltó la aceptación positiva que tienen estos productos en el campo. “La respuesta de los productores a estos productos es muy buena, ya que estamos hablando del futuro de la agricultura. Cada vez el mundo exige más alimentos, pero alimentos más sanos, y los bioinsumos te permiten producir alimentos más sanos porque no afectan al medio ambiente ni al desarrollo del producto, y permiten mayor calidad”.
Además del impacto positivo en el rendimiento y la sostenibilidad, los bioinsumos también representan una opción económicamente accesible. “Por otro lado, los bioinsumos tienen un costo mucho más bajo porque se trata de microorganismos naturales y la fábrica de multiplicación está en Bolivia”, añadió.
En definitiva, el uso de bioinsumos no solo fortalece la seguridad alimentaria mediante la producción de cultivos más sanos, sino que también dinamiza la economía de los productores, reduce la dependencia de insumos químicos importados y contribuye a la preservación de los recursos naturales.
Fuente: Oscar Navia
Redacción: Publiagro













